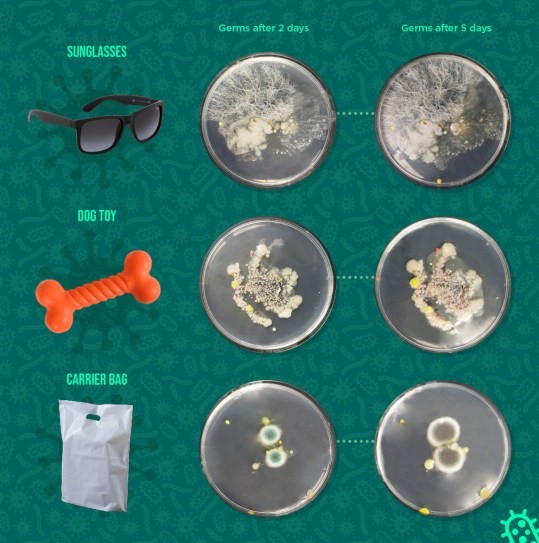
Cinq moyens fiables de se débarrasser des germes et une liste des objets les plus dangereux de la maison
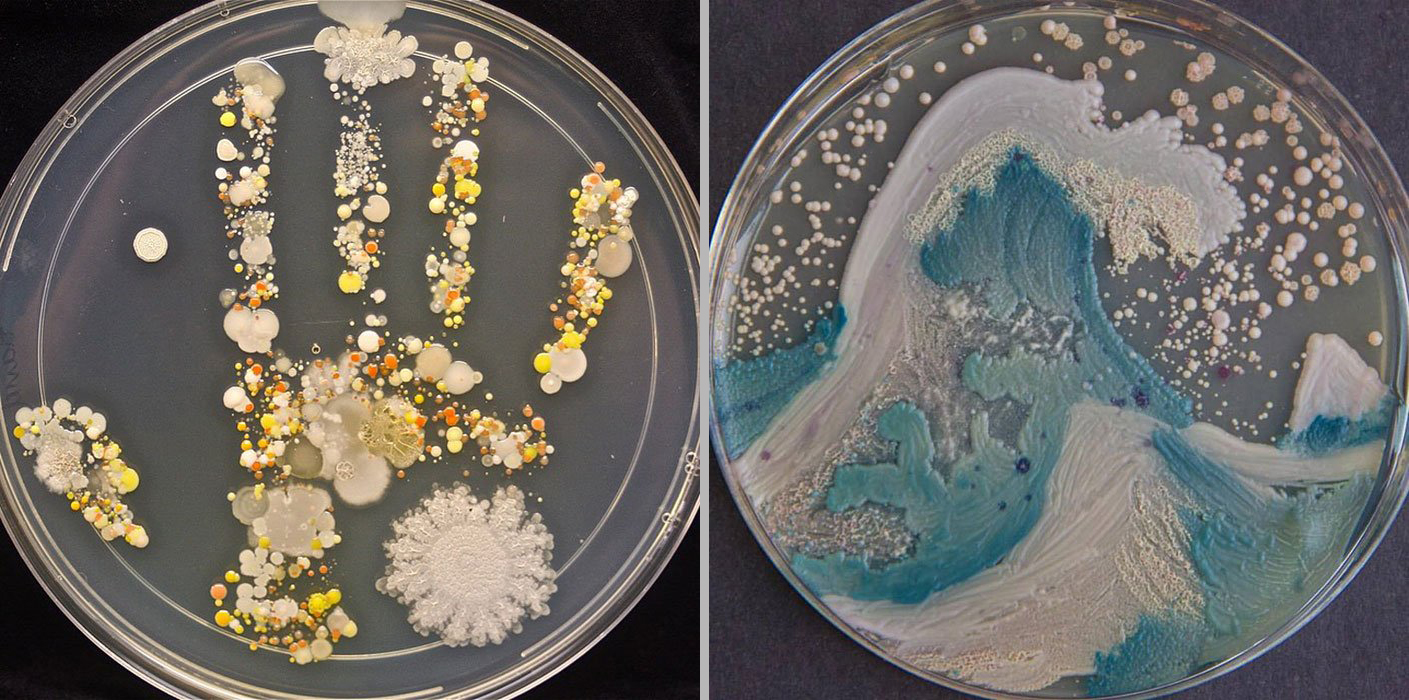
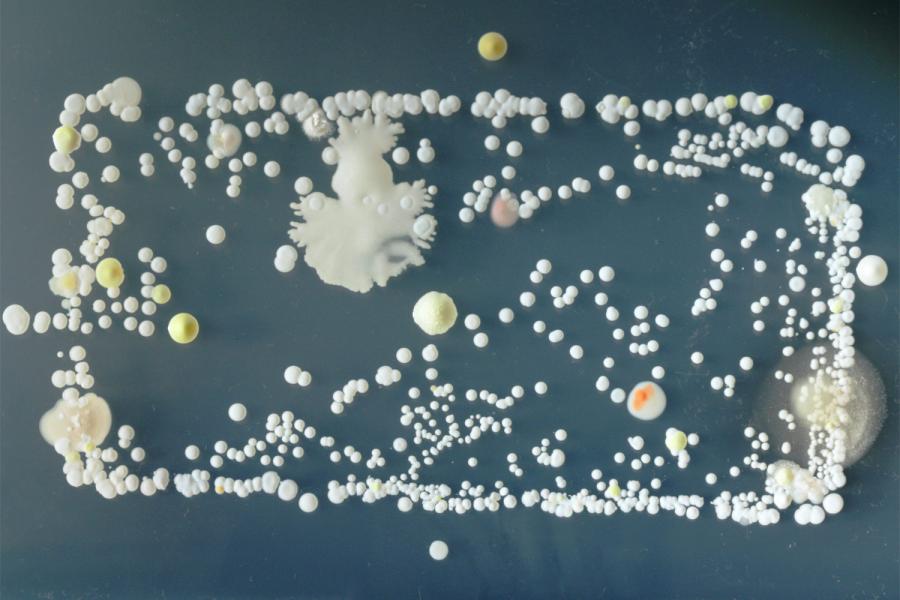

- Jouets de bain et rideaux de douche
- Combien de temps faut-il se laver les mains pour tuer tous les germes ?
- Examen
- Virus du rhume
- Virus de la grippe
- Infections intestinales
- SARM (Staphylococcus aureus résistant à la mécitilline)
- Herpès
- Limiter la propagation de l'infection
- Salles de bain
- VIH
- Erreurs de lavage courantes
- Pouvez-vous jeter du papier toilette dans les toilettes ?
- Grille d'âme
- Évier de cuisine
- Connaître l'ennemi de vue
- Pourquoi devriez-vous abaisser le couvercle des toilettes avant de tirer la chasse ?
- Souris et claviers d'ordinateur
- Cela peut-il être jeté dans les toilettes ?
- Où se trouve le plus de bactéries sur le corps humain
- Où se trouve le plus de bactéries à l'extérieur de la cuisine
- 5 façons de désinfecter
- Véhicules
- Étude
- Les eaux usées sont une menace pour la santé
- Comment essuyer ?
- Conclusion
Jouets de bain et rideaux de douche
L'humidité et la chaleur font de votre salle de bain un terreau idéal pour les germes, les bactéries et les champignons. Une étude de 2018 a trouvé 75 millions de cellules bactériennes par centimètre carré de divers jouets de bain. L'étude a également trouvé des champignons dans 60% des jouets.
Pour réduire les germes, achetez des jouets de bain qui n'ont pas de trou pour vous permettre de les remplir d'eau, rincez-les régulièrement avec un désinfectant et assurez-vous qu'ils sont complètement secs après utilisation.
Une autre étude, publiée en 2014 dans le Journal of Clinical Microbiology, a révélé que la surface des rideaux de douche en vinyle peut abriter une gamme de microbes, notamment des méthylobactéries (un groupe de bactéries pouvant provoquer des infections). Nettoyez régulièrement vos rideaux pour la douche avec des nettoyants désinfectants.

Combien de temps faut-il se laver les mains pour tuer tous les germes ?

Vous êtes-vous déjà demandé pourquoi il est si important d'utiliser du savon pour se laver les mains ? Peu de gens savent que le savon ne tue pas les bactéries, mais les élimine de la surface des mains. La molécule de savon résout deux problèmes à la fois : elle se lie à l'eau et à la saleté
Grâce à leur texture collante, les molécules de savon extraient les germes des dépressions de la peau. Après cela, ils sont lavés à l'eau et les mains deviennent propres.

Aujourd'hui, de nombreuses entreprises essaient de nous convaincre d'acheter du savon antibactérien. En fait, il s'agit d'un stratagème marketing, grâce auquel nous surpayons une somme importante pour de beaux emballages avec un slogan convaincant et la promesse du fabricant. Les ingrédients antibactériens n'ajoutent pas d'efficacité. Par conséquent, ne payez pas trop cher, mais achetez le savon le plus ordinaire.
Selon Myasnikov, les rumeurs sur les dangers catégoriques de la viande sont exagérées
Le British Museum a enregistré la trouvaille d'un homme : le sceau du pape de Rome, XIIIe siècle.
L'été on passe au café infusé à froid : 3 recettes d'infusion froide avec de la glace
Examen
Tout dépend du type de bactérie ou de virus et de la surface sur laquelle ils se trouvent. La plupart des bactéries, virus et champignons pathogènes ont besoin de conditions humides pour vivre, donc combien de temps ils peuvent vivre en dehors du corps dépend de l'humidité de l'air et surfaces.
Virus du rhume
Il a été démontré que les virus du rhume vivent sur les surfaces intérieures pendant plus de sept jours. De manière générale, les virus vivent plus longtemps sur des surfaces lisses (résistantes à l'eau) telles que l'acier inoxydable et le plastique que sur des surfaces poreuses telles que les tissus et les tissus. Bien que les virus du rhume puissent vivre sur des surfaces pendant plusieurs jours, leur capacité à provoquer des maladies commence à décliner après 24 heures.
À la surface des mains, la plupart des virus du rhume vivent beaucoup moins. Certains d'entre eux ne survivent que quelques minutes, mais 40 % des rhinovirus, pathogènes du rhume, sont encore contagieux sur les mains pendant une heure.
Le virus respiratoire syncytial (VRS), un autre virus semblable au rhume qui provoque parfois des maladies graves chez les enfants, peut vivre sur la table du dîner jusqu'à six heures, sur du tissu et du papier pendant 30 à 45 minutes et sur la peau jusqu'à 20 minutes. minutes.
Virus de la grippe
Les virus de la grippe se transmettent par les mains et infectent le corps humain. Sur les surfaces dures, ils peuvent vivre 24 heures. Les virus de la grippe peuvent vivre sur les tissus pendant seulement 15 minutes.
Comme les virus du rhume, les virus de la grippe vivent beaucoup moins sur les mains. Après que le virus de la grippe a été entre les mains d'une personne pendant cinq minutes, sa concentration diminue fortement.
Les virus de la grippe peuvent vivre dans des gouttelettes d'humidité volant dans l'air pendant plusieurs heures, et à basse température, ils vivent encore plus longtemps.
Le virus parainfluenza, l'agent causal du croup chez les enfants, peut vivre jusqu'à 10 heures sur des surfaces dures et jusqu'à quatre heures sur des surfaces molles.
Infections intestinales
Les infections intestinales peuvent être causées par divers micro-organismes, notamment des bactéries telles que E. coli, Salmonella, C. difficile et Campylobacter, ainsi que des virus tels que les norovirus et les rotavirus.
Salmonella et Campylobacter peuvent vivre environ 1 à 4 heures sur des surfaces et des tissus durs, tandis que les norovirus et C. difficile peuvent vivre beaucoup plus longtemps. Selon une étude, Clostridium difficile peut survivre jusqu'à cinq mois. Le norovirus peut vivre des jours voire des semaines sur des surfaces dures.
Lorsqu'une personne infectée par le norovirus vomit, le virus se propage dans l'air en petites gouttelettes d'humidité.
Ces gouttelettes atterrissent ensuite sur les surfaces et c'est ainsi que le virus se propage, il est donc important d'essuyer soigneusement toutes les surfaces si un membre de votre famille a contracté le norovirus.
Pour prévenir la propagation d'une infection intestinale, lavez-vous les mains régulièrement et soigneusement, surtout après être allé aux toilettes. Il est également nécessaire de maintenir une bonne hygiène alimentaire.
SARM (Staphylococcus aureus résistant à la mécitilline)
Staphylococcus aureus, la bactérie responsable des infections à SARM, peut vivre sur des surfaces pendant des jours, voire des semaines. Les bactéries SARM peuvent vivre plus longtemps sur les surfaces que certaines bactéries et certains virus, car elles se portent mieux sans humidité. Les bactéries SARM vivent généralement plus longtemps sur les surfaces dures que sur les surfaces molles.
Herpès
Les virus de l'herpès des plaies autour de la bouche peuvent vivre quatre heures sur du plastique, trois sur du tissu et deux sur la peau. Si vous avez une fièvre herpétique, ne touchez pas les cloques.Si vous les touchez, par exemple pour appliquer une crème contre les boutons de fièvre, assurez-vous de vous laver les mains. juste après cette.
Limiter la propagation de l'infection
Éviter l'infection n'est pas toujours possible, mais il est possible d'en réduire le risque et d'empêcher d'autres personnes d'être infectées. Pour ça:
- Lavez-vous les mains régulièrement, surtout après être allé aux toilettes, avant de manipuler des aliments et après avoir toussé, éternué ou vous être mouché.
- Gardez votre maison propre, surtout si l'un des membres de votre famille est malade.
- Lavez les tissus susceptibles d'avoir été contaminés par des bactéries ou des virus à une température d'au moins 60 ºC avec un détergent contenant de l'eau de Javel.
Salles de bain
Vous pourriez être surpris d'apprendre que les salles de bains ne sont que le 11ème endroit le plus dangereux de la maison, car les bactéries se développent dans les environnements humides et les liquides dans la salle de bain sont plus que suffisants. Cependant, être dans la salle de bain est relativement sûr.

Bien sûr, il y a beaucoup de bactéries là-bas, bien qu'elles ne représentent pas une menace particulière, si tu le fais régulièrement nettoyage de la maison. Il est recommandé d'essuyer toutes les surfaces de la salle de bain avec un désinfectant au moins une fois par semaine. Soit dit en passant, l'endroit où le plus grand nombre de bactéries s'accumulent dans la salle de bain sont les tapis de salle de bain. Nettoyez-les ou lavez-les régulièrement avec des désinfectants - ajoutez-les simplement à n'importe quel détergent.

VIH
Peut-être que la plus grande préoccupation de l'humanité est causée par l'infection par le VIH. Et c'est avec elle qu'un grand nombre de mythes concernant les méthodes d'infection sont associés. Beaucoup de gens pensent qu'il peut pénétrer dans le corps après avoir touché les mains courantes du métro ou des transports en commun.D'autres sont convaincus que les insectes (moustiques, punaises de lit, poux) peuvent devenir une source d'infection.
Cependant, les résultats de nombreuses études prouvent que dans l'environnement extérieur, le VIH est une infection instable. Dans les zones ouvertes, 90 à 99 % des bactéries qui causent la maladie meurent en quelques heures. De plus, de telles expériences utilisent une concentration de cellules VIH plus élevée qu'elle ne l'est réellement. Pour cette raison, les scientifiques sont arrivés à la conclusion qu'il est presque impossible pour une personne en bonne santé d'être infectée dans l'environnement sans avoir des rapports sexuels avec un partenaire infecté.
À l'extérieur du corps, le virus fragile meurt lorsqu'il est exposé à l'alcool à friction, à l'eau chaude, au savon et aux désinfectants.
Si les rapports sexuels sans contraceptifs sont exclus, seules les seringues infectées présentent le plus grand danger. Dans l'aiguille, le sang infecté ne se dessèche pas pendant plusieurs jours et les agents pathogènes du VIH peuvent survivre. C'est pourquoi, pour votre propre sécurité, vous ne devez utiliser que des seringues et des aiguilles jetables pour le matériel médical et cosmétique.
les agents pathogènes ont besoin conditions favorables pour fonctionnement et reproduction - le corps humain est un lieu de vie idéal pour eux. En quittant le corps, les micro-organismes et les bactéries sont incapables de mener une vie active. C'est pourquoi les IST ne doivent pas faire peur à ceux qui sont vigilants et protégés.
Erreurs de lavage courantes
- À l'heure actuelle, il y a une tendance à réduire la température et la quantité d'eau consommée pour le lavage, ainsi que l'utilisation de détergents neutres, ce qui, bien sûr, a un effet positif sur l'efficacité du lavage, mais en même temps s'aggrave la qualité de l'élimination des bactéries nocives des vêtements;
- Un cycle de lavage fermé a également un effet négatif sur l'élimination des germes nocifs. Si vous chargez un article sale dans la machine à laver, pendant le lavage, toute la saleté sera répartie sur le reste des vêtements. Ainsi, une soi-disant «soupe bactérienne» est créée dans laquelle les bactéries sont «bouillies» et se multiplient;
- Il arrive souvent que des vêtements ou des accessoires contaminés par des microbes en contact direct avec le corps apportent diverses maladies virales à une personne. Les bactéries à l'intérieur de la machine peuvent également être responsables de la contamination croisée du linge. Des études ont confirmé que les microbes qui vivent à l'intérieur des machines à laver s'accumulent dans l'eau restante du lavage ;
- Une température de lavage basse est une bonne condition pour la propagation des bactéries. Ils apprécient particulièrement le compartiment à lessive et la gomme d'étanchéité de la porte. Il existe également un grand risque de reproduction de micro-organismes nuisibles pendant le lavage si vous ajoutez un article d'un membre malade de la famille. Il est recommandé de toujours séparer les sous-vêtements utilisés par une personne malade du reste pour éviter la propagation des infections virales.
Pouvez-vous jeter du papier toilette dans les toilettes ?
Le papier toilette peut parfois conduire à des toilettes bouchées. Cela s'applique principalement aux types de papier hygiénique plus anciens et plus rigides. Le papier hygiénique moderne a tendance à se dissoudre dans l'eau et peut être jeté dans les toilettes.
Quand peut-on jeter du papier toilette ?
-
Si les toilettes sont raccordées à l'égout central d'un immeuble à appartements
-
Si les toilettes sont reliées à un égout local avec un court trajet, où elles se dissolvent à l'aide de fosses septiques actives.
Quand ne faut-il pas jeter du papier toilette dans les toilettes ?
-
Le papier se retrouve dans le réservoir de stockage et ne va pas directement dans les égouts
-
L'égout local contient des rebondissements sur le chemin du réservoir
-
Le petit diamètre du tuyau d'égout (moins de 10 cm) et la longueur du tuyau sont supérieurs à 5 mètres.
Grille d'âme
L'année dernière, des scientifiques du Boston Simmons College Hygiene Center (États-Unis) ont examiné les salles de bain de plusieurs milliers de volontaires et ont trouvé des bactéries Staphylococcus aureus chez environ un quart d'entre eux. Des micro-organismes se sont multipliés sur les pommeaux de douche et à chaque inclusion d'eau sont tombés sur la peau des propriétaires des appartements. Ils ont également pris goût aux coins, aux crevasses entre les carreaux, aux joints d'étagères, aux drains et autres endroits "isolés" difficiles à nettoyer et constamment humides.
Que faire. Lavez la salle de bain avec des désinfectants une fois par semaine et aérez-la constamment pour éviter la stagnation de l'humidité. Si les fonds le permettent, vous pouvez installer un petit ventilateur dans la hotte qui fonctionnera automatiquement. chaque fois que tu allumes la lumière. Une option moins chère consiste simplement à garder la porte de la salle de bain ouverte.
Évier de cuisine
Tel que calculé par des scientifiques anglais curieux, sur un carré En moyenne, jusqu'à 80 000 bactéries vivent dans un centimètre de surface à proximité et à l'intérieur du drain de la cuisine. Les micro-organismes se nourrissent volontiers des restes de produits, qui sont très, très difficiles à laver complètement, et se multiplient rapidement dans un environnement fertile.
De nombreuses infections peuvent également se trouver sur le robinet, où la saleté, les éclaboussures et, encore une fois, les déchets alimentaires se retrouvent lors du lavage de la vaisselle. Mais par-dessus tout, l'infection aime les éponges et les chiffons de table qui ne dessèchent pas et qui sont constamment sales : ironiquement, ce sont les produits de nettoyage qui deviennent les sources de saleté les plus problématiques.
Que faire. Ne soyez pas paresseux et nettoyez l'évier et le robinet après chaque cuisson ou lavage de la vaisselle. Et pas seulement rincer à l'eau tiède : oui, l'eau peut laver les germes, mais les micro-organismes vont se coincer quelque part dans le drain, commencer à se multiplier et remonter rapidement à la surface. Mais les détergents, sous forme de gel ou de poudre, aideront à tuer l'infection - comme vous le souhaitez.
Et n'oubliez pas de rincer vos éponges et chiffons une fois le nettoyage terminé.
Connaître l'ennemi de vue
Les humains sont entourés de bactéries et de virus nocifs. Le risque de les affronter en tête-à-tête est assez élevé. Quels microbes sont les plus dangereux ?

Top 10 des bactéries qui détruisent la santé :
Staphylococcus aureus. C'est l'agent causal d'un certain nombre de maladies infectieuses dangereuses. Provoque une septicémie, qui est très difficile à traiter avec des médicaments. Il est particulièrement dangereux pendant la grossesse pour la mère et le fœtus.
Salmonelle. Il affecte le tractus gastro-intestinal, provoque une intoxication générale du corps. Les symptômes de la maladie peuvent apparaître à la fois immédiatement après l'infection et après quelques jours. La source d'infection sont les produits laitiers, la viande, l'eau brute. Pendant la grossesse, une déshydratation sévère peut entraîner une fausse couche.
Bâton antitétanique. Provoque une maladie appelée tétanos. L'infection met la vie en danger car la bactérie libère un poison extrêmement toxique qui paralyse le système nerveux.L'agent pathogène se sent bien dans le sol, en particulier dans les zones rurales. Le facteur d'infection est de marcher pieds nus sur le sol. Si une infection est suspectée, les personnes reçoivent le vaccin antitétanique.
Bâton de Koch. Il pénètre dans l'organisme par des gouttelettes en suspension dans l'air et cause la tuberculose des poumons, des reins, des ganglions lymphatiques, de la peau et des os. Les symptômes cliniques sont flous, de sorte que la population subit un examen annuel pour l'infection. Pendant la grossesse, cela peut entraîner des dommages dangereux au tissu pulmonaire et une insuffisance respiratoire.
Tréponème pâle. Provoque la syphilis, une maladie sexuellement transmissible. Il est transmis sexuellement ou par voie domestique. La période d'incubation est de 3 semaines. Pendant la grossesse, cela entraîne de graves dommages pour le fœtus, de sorte qu'une détection précoce de la maladie peut sauver l'enfant à naître.
Campylobacter. Provoque une grave intoxication alimentaire. L'infection se produit lors de la consommation de viande de poulet crue ou mal cuite. Il se multiplie très rapidement dans le tube digestif humain, de sorte que les symptômes apparaissent dès 5 jours après l'infection.
Helicobacter pylori. Localisé sur les parois de l'estomac. Se sent bien dans un environnement gastrique acide. Il se transmet par contact de personne à personne par la salive. Provoque une érosion et des ulcères qui provoquent des brûlures d'estomac, des nausées, des vomissements, une intolérance à la viande. Pendant la grossesse, les symptômes de la maladie s'aggravent, mais ne constituent pas un facteur de risque pour le fœtus. Le traitement repose sur des antibiotiques et une alimentation prudente.
Vibrio cholerae. Il affecte le tractus gastro-intestinal, provoquant des diarrhées et une déshydratation sévère. Peut entraîner la mort du patient.L'infection se produit en raison de la consommation d'eau contaminée.
Salmonella enterica. C'est le coupable de la fièvre typhoïde, qui affecte les organes abdominaux avec de fortes toxines. Il se sent bien dans l'eau douce, il pénètre donc le plus souvent dans le corps en buvant de l'eau brute. La fièvre typhoïde est assez rare. Cependant, nous ne devons pas perdre notre vigilance
Une attention particulière est portée à patientes pendant la grossesse. Parce que les toxines peuvent non seulement provoquer des saignements et une naissance prématurée, mais aussi entraîner la mort de la mère.
Shigelle
L'agent causal de la maladie intestinale est la dysenterie. Bien conservé dans la nourriture et l'eau. Les porteurs de la maladie sont des personnes infectées par la shigelle. Dans la plupart des cas, les enfants sont touchés. La maladie peut se prolonger jusqu'à 3-4 semaines.

Pourquoi devriez-vous abaisser le couvercle des toilettes avant de tirer la chasse ?
Les scientifiques ont découvert que lors du rinçage avec le couvercle ouvert l'eau du réservoir melanger avec eau de toilette, et les gouttelettes montent d'au moins 10 centimètres. Naturellement, ils se dispersent dans la salle de bain et se déposent sur tout, y compris le rouleau de papier toilette et le sol. C'est ce qu'on appelle le "panache des toilettes".
Étant donné que dans les toilettes publiques, il est impossible de contrôler qui tire la chasse et comment, il est préférable de ne pas poser d'objets personnels sur le sol ou un réservoir, et à la fin du processus, se laver les mains à l'eau chaude et au savon. L'Organisation mondiale de la santé conseille de chanter lentement "Joyeux anniversaire" (enfin, ou "Laissez-les courir maladroitement") afin de détecter les 20 secondes nécessaires au lavage, et de bien se laver entre les doigts.
Texte : Tamara Kolos
Couverture : Charles Deluvio
Souris et claviers d'ordinateur
Vous pensez à peine aux germes sur vos objets que vous utilisez tous les jours. Par exemple, à propos de la souris et du clavier de l'ordinateur, qui sont utilisés à notre époque, peut-être plus que d'autres choses. De plus, ce sont leurs gens qui nettoient soit extrêmement rarement, soit jamais du tout.

En conséquence, un grand nombre d'agents pathogènes se multiplient à proximité de votre ordinateur. Bien sûr, la fréquence et la diligence du nettoyage jouent ici un grand rôle.
C'est vraiment important, alors prenez votre temps et faites-le avec soin. Les sprays ne peuvent pas être utilisés dans cette situation, donc la seule issue est d'utiliser des cotons-tiges imbibés de désinfectant afin de pouvoir nettoyer soigneusement l'espace entre les boutons du clavier.

Comme tout le reste, il est recommandé de nettoyer un clavier et une souris d'ordinateur au moins une fois par semaine.
Cela peut-il être jeté dans les toilettes ?
1. Lingettes humides
Les lingettes humides sont un article d'hygiène assez populaire. Même si certains fabricants prétendent qu'ils peuvent être rincés comme du papier toilette, ces lingettes créent des blocages et obstruent les drains.
Beaucoup de gens ne veulent pas jeter de lingettes humides dans le panier s'ils les utilisent à des fins d'hygiène. Cependant, les fibres des lingettes humides sont beaucoup plus épaisses que le papier toilette et ne se dissolvent pas dans l'eau.
2. Préservatifs
Ils semblent assez petits et fins, mais ce produit au latex peut contribuer à la formation de ce qu'on appelle des bouchons de graisse dans le drain. De plus, ces produits se gonflent facilement, et si le préservatif est noué, il peut se remplir d'eau et boucher simplement le drain.
3. Des cotons-tiges
Ils sont en coton, pensez-vous.De plus, ils ont l'air très petits et il est peu probable qu'ils obstruent les tuyaux. Croyez-moi, ce n'est pas le cas. Au fil du temps, ils s'accumulent simplement dans les coudes des tuyaux, provoquant des blocages massifs.
4. Médicaments
Avez-vous besoin de médicaments supplémentaires? De nombreuses personnes choisissent de se protéger ou de protéger leur foyer en jetant des médicaments dans les toilettes. Cependant, cette habitude est très dangereuse.
Dans les égouts, des processus biologiques complexes de décomposition des déchets ont lieu et les médicaments interfèrent avec ces processus.
Les médicaments antibactériens créent des microbes résistants aux antibiotiques, pénètrent dans les plans d'eau, les lacs, les rivières et les mers et ont un effet néfaste sur les habitants de l'eau, puis sur les humains.
5. Serviettes en papier
Les serviettes en papier sont beaucoup plus rigides que le papier toilette et ne se dissolvent pas aussi facilement dans l'eau que le papier toilette. Certains types de serviettes en papier sont suffisamment solides pour contenir une boule de bowling, et même les types biodégradables peuvent entraîner des obstructions majeures.
6. Mégots de cigarettes
Non seulement ils gâchent la vue lorsqu'ils flottent dans l'eau des toilettes, mais ils contiennent également de nombreux produits chimiques toxiques, notamment du goudron et de la nicotine, qui se retrouvent ensuite dans la plomberie et se retrouvent dans notre eau.
7. Pansements adhésifs
Les pansements adhésifs sont en plastique non biodégradable dans l'environnement.
Ils ont également la capacité de coller à d'autres objets dans les égouts, et de petits morceaux se transforment immédiatement en énormes blocages. Jetez-les à la poubelle, c'est là qu'ils appartiennent.
Où se trouve le plus de bactéries sur le corps humain
Récemment, des chercheurs ont pu déterminer où vivent la plupart des bactéries sur le corps humain. Les résultats ont été très surprenants, puisque ce n'étaient même pas les aisselles, dont il a été question plus haut, mais les sections des bras allant du poignet au coude.C'est sur cette zone de la peau que les scientifiques ont pu détecter 44 espèces de bactéries.
Les conditions de l'étude supposaient que tous les participants à l'expérience se lavaient avec le même savon pendant une semaine et ne se lavaient pas du tout le dernier jour. Après cela, ils ont donné aux chercheurs la possibilité de prélever des écouvillons de toutes les parties du corps à des fins de comparaison. L'expérience a abouti à la découverte d'environ 100 micro-organismes différents. Dans le même temps, la plupart des bactéries différentes ont été trouvées sur la peau du poignet au coude. Cet état de fait est probablement dû au fait que cette partie des mains entre souvent en contact avec d'autres objets. Dans le même temps, peu de personnes se lavent les mains jusqu'aux coudes aussi souvent que leurs paumes.
Les scientifiques ont également été surpris qu'il n'y ait plus de bactéries sur les zones grasses de la peau, et encore moins que sur les zones sèches. Et le plus propre était la peau derrière les oreilles. Pas plus de 15 espèces de bactéries vivent dans cet endroit.
Où se trouve le plus de bactéries à l'extérieur de la cuisine
Ne pensez pas que la cuisine est l'endroit le plus pollué de la maison et des environs. Il existe de nombreux endroits qui peuvent nous sembler tout à fait propres, mais en fait, il peut y avoir une énorme quantité de bactéries. Où sont ces lieux ?
Beaucoup de bactéries se cachent dans les machines à laver. Ce n'est pas surprenant, car nous y chargeons du linge sale, et parfois il peut y rester assez longtemps sans accès à la lumière et à l'air frais, ce qui crée d'excellentes conditions pour la reproduction des bactéries.
Étonnamment, beaucoup de bactéries se cachent dans nos voitures. Beaucoup de bactéries sur les leviers de vitesses et sur les tableaux de bord.Des régimes de température et de ventilation appropriés, ainsi que le renouvellement constant des bactéries apportées sur les mains, leur permettent de créer de très grandes colonies à ces endroits.
 L'intérieur de la voiture est un lieu de danger bactérien accru
L'intérieur de la voiture est un lieu de danger bactérien accru
En général, l'intérieur de la voiture est un endroit plutôt dangereux par rapport aux bactéries. Surtout si de jeunes enfants y montent souvent. Les sièges d'auto pour enfants sont un autre lieu d'accumulation importante de bactéries. Les enfants éparpillent souvent de la nourriture, bavent des chaises, enduisent le tout avec leurs mains, créant ainsi un environnement unique pour les bactéries. Par conséquent, les sièges pour enfants doivent être nettoyés aussi souvent que possible.
Beaucoup de bactéries sur les sacs à main, les portefeuilles et les téléphones. Souvent, nous les mettons à côté de nous, sans penser à la propreté de la surface. Et nous pensons généralement à laver les sacs ou à désinfecter les téléphones rarement.
5 façons de désinfecter
Les bactéries, virus, champignons et autres agents pathogènes sont tout autour de nous. Ils sont invisibles à l'œil nu, mais très dangereux. Avec une désinfection insuffisante, la probabilité de contracter une infection intestinale, le SRAS, la tuberculose, ainsi que des maladies dont souffrent les autres résidents de la maison, augmente.
Mais comment se débarrasser des germes dans l'appartement ? Il existe 5 méthodes fiables :
- Moyens chimiques. Toutes les solutions et tous les produits contenant du chlore conviennent à la désinfection: "Whiteness", "Sanita", "Shine" et autres. Des études récentes de contrôle sanitaire et épidémiologique ont prouvé que les solutions contenant du chlore sont les seuls produits ménagers connus de la science moderne capables de tuer absolument tous les germes et infections.

Lavage.La lutte contre les agents pathogènes comprend le lavage régulier des sous-vêtements et du linge de lit, des rideaux, des housses amovibles, des peluches.

Ébullition. La plupart des microbes meurent instantanément dans l'eau bouillante. C'est le moyen le plus simple et le plus fiable de désinfecter les jouets, les outils, les ustensiles, les tétines et les biberons.

Quartzisation par rayonnement ultraviolet d'une lampe bactéricide (recirculateur). Les molécules d'ADN microbien sont détruites lorsque les rayons UV sont absorbés. Lorsqu'ils sont traités pendant 15 à 20 minutes, les virus, les bactéries, les moisissures et les champignons meurent dans l'air et sur les surfaces.

Lavage à l'air. Le purificateur et humidificateur élimine la poussière, les bactéries, les allergènes et autres substances nocives dans l'air. L'évier fait passer l'air à travers le filtre, ce qui est un avantage tangible par rapport à l'humidificateur classique.


Véhicules
Évitez de toucher les tables et les sièges des transports en commun, les stores et les boutons qui contrôlent les fonctions d'éclairage et l'inclinaison du siège. Ces surfaces sont toujours touchées par de nombreux voyageurs qui n'ont peut-être pas les mains les plus propres.
Essuyez les boutons, les commandes et les rideaux avant utilisation et immédiatement après vous être assis dans votre siège. Lavez-vous les mains ou utilisez un désinfectant pour les mains à base d'alcool. De telles habitudes saines aideront non seulement à vous protéger, mais aussi aux autres, contre les infections, ainsi qu'à arrêter le transfert de bactéries. L'habitude de l'hygiène solidaire est très bénéfique pour vous et les autres.
Mais ne pensez pas que ce n'est pas parce que vous utilisez des désinfectants que vous pouvez tomber malade.
Essuyez périodiquement les surfaces de la voiture avec des lingettes à base d'alcool.Et si vous prenez un taxi, lavez-vous les mains ou utilisez un désinfectant pour les mains après avoir touché les poignées de porte et d'autres parties de la cabine.

Étude
Il est assez difficile d'accuser les scientifiques britanniques qui ont mené l'étude avec l'échantillonnage de matériel microbiologique de leur parti pris ou de la soumission d'informations délibérément fausses. Depuis les travaux ont testé des échantillons prélevés sur trois mille appareils mobiles appartenant à des citoyens moyens. De la surface de chaque gadget, les chercheurs ont prélevé un écouvillon et compté les variétés de bactéries. Les chercheurs ont également prélevé des écouvillons dans 100 toilettes publiques à Londres.
C'est beaucoup moins, mais cela n'affecte pas l'importance de l'étude.
L'expérience s'est bien passée : un nouveau film hollywoodien tourné à la maison
Shampoing solide aux huiles et aux herbes fait maison : je l'utilise depuis trois ans et je ne regrette rien
L'enseigne mange des pommes, et récupère les graines dans un sac : une blague militaire
Après avoir comparé les analyses prises sur les smartphones et les toilettes, les chercheurs ont conclu que le nombre de micro-organismes nocifs sur les téléphones portables est 18 fois plus élevé. Parmi les échantillons étudiés figuraient des appareils tellement contaminés qu'il était étrange que leurs propriétaires ne se soient pas encore retrouvés dans un lit d'hôpital avec un trouble intestinal. Entre autres choses, les chercheurs ont trouvé des salmonelles, E. coli et Staphylococcus aureus sur des appareils mobiles. Ce sont des bactéries dangereuses qui peuvent causer des maladies telles que la méningite, les infections cutanées, la pneumonie et les troubles gastro-intestinaux aigus.

Les eaux usées sont une menace pour la santé
Le principal inconvénient de la construction de logements privés est le manque d'égouts. Les conteneurs dans lesquels s'accumulent les eaux usées domestiques constituent le meilleur environnement pour les bactéries pathogènes.Ceci est facile à vérifier en regardant une photo avec une image agrandie des habitants des eaux usées. De plus, des effluents contaminés par des bactéries pénètrent dans le sol et les eaux souterraines, infectant les plantes sur le site. Dans de telles conditions, la probabilité de contamination bactérienne sur la peau humaine et l'infection subséquente du corps est très élevée.
Y a-t-il une issue ? Oui. C'est l'utilisation d'une fosse septique (puisard). Comme on peut le voir sur la disposition de la photo, il s'agit d'un conteneur de plusieurs chambres communicantes internes avec des cloisons. Le plus souvent, des fosses septiques à deux ou trois compartiments sont utilisées. Il s'agit d'une conception simple avec un tuyau pour l'afflux des eaux usées domestiques et le retrait du liquide purifié. Une fosse septique vous permet de concevoir de vos propres mains votre propre système d'égout sur votre site.
Le modèle de fonctionnement du système est le suivant :
- Les eaux usées domestiques par un système de canalisation pénètrent dans la première chambre de la fosse septique.
- Dans celui-ci, le contenu est déposé avec séparation dans la partie liquide et les sédiments.
- De plus, le liquide et les particules en suspension s'écoulent dans le deuxième compartiment de la fosse septique.
- Ici, il est nettoyé par des bactéries qui décomposent la matière organique entrante.
- Dans la troisième section de la fosse septique (le cas échéant), les eaux traitées décantent et sont évacuées.
Le degré de purification dépend de la contamination et de la composition des eaux usées, du modèle de fosse septique installé, du nombre de chambres et du type de bactéries utilisées dans les préparations bioenzymatiques.

Les boues de décantation doivent être retirées du puisard 1 à 2 fois par an. Le liquide obtenu à la sortie de la fosse septique doit subir un post-traitement du sol. L'utilisation d'un puisard permet d'atteindre un confort urbain sur chalet sans besoin de pompage constant drains.
Comment essuyer ?
Vous devez d'abord déconnecter votre smartphone du réseau et éteindre l'alimentation. S'il y a un couvercle, retirez-le et vaporisez un peu du produit sélectionné à une distance de 20-30 cm ou humidifiez un chiffon avec. Après cela, le gadget est effacé de tous les côtés. N'appliquez pas trop de liquide sur le tissu, sinon un excès d'humidité pourrait pénétrer dans les haut-parleurs ou la prise de charge. Vous n'avez pas besoin d'ouvrir l'arrière de l'appareil, seules les surfaces extérieures doivent être nettoyées.
Si vous avez l'habitude d'utiliser une housse, celle-ci doit être retirée au moins une fois par semaine et traitée avec un coton imbibé d'une solution d'alcool.
Faites attention au film protecteur. La saleté s'accumule autour de son périmètre et les bactéries se concentrent dans les rayures sur le boîtier
L'écran est constamment en contact avec le visage pendant une conversation, ainsi les germes pénètrent sur la peau
Par conséquent, il est important de mettre à jour le film plus souvent.

Essayez de ne pas partager votre appareil avec d'autres personnes. Ce n'est pas parce que vous avez l'habitude de vous laver les mains après être allé aux toilettes que tout le monde le fait. Par conséquent, moins les étrangers utilisent votre gadget, mieux c'est.
Conclusion
Bien sûr, une technique de lavage des mains approfondie aidera à nettoyer vos mains et à éliminer certaines des bactéries à leur surface. Mais si vous y réfléchissez, en 30 secondes, vous pouvez non seulement éliminer les germes, mais aussi vous sécher les mains. Si vous avez la peau sèche, n'augmentez pas le temps de lavage à 30 secondes, mais limitez-vous à 15. Faites juste bien mousser les pinceaux et traitez soigneusement les zones entre les doigts, ainsi que les endroits sous les ongles et les cuticules. Ce n'est qu'ainsi que vous pourrez éliminer le maximum de bactéries et protéger votre corps de la pénétration de microbes pathogènes, d'agents pathogènes potentiels.
Assurez-vous de vous laver les mains après avoir été en contact avec d'autres personnes et après avoir utilisé les transports en commun. Rappelez-vous que même une simple poignée de main peut causer des maladies. N'oubliez pas la procédure d'hygiène après la toilette, surtout après la toilette publique. Il est préférable de se sécher les mains avec une serviette. Une friction supplémentaire renforcera l'effet de la procédure d'hygiène et éliminera les bactéries résiduelles.

![[instruction] installation de toilettes à faire soi-même | vidéo](https://fixit.tomathouse.com/wp-content/uploads/e/0/5/e05c3aaa569c15a65a76abf551b1139c.jpg)
